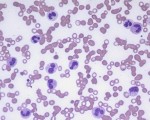
Neutrophilia - leukemoid reaction

Featured Articles
 11 years ago
11 years agoWhite blood cells: Description, Classification and Formation
 11 years ago
11 years agoBlood Cells and Platelets
 11 years ago
11 years agoGram stain of wound specimen
All Stories

Basophilic Stippling
the round, dark-blue granules known as basophilic stippling
The granules are composed of precipitated ribosomes and mitochondria in immature red blood cells
Basophilic Stippling ...

Blasts from acute lymphocytic leukemia ALL patient
This smear taken from acute lymphocytic leukemia (ALL) patient
when we first report the cell we say it’s blast but we don’t specify it until we do other tests but i put ...

Stomatocytes on blood smear
Stomatocytes: [fish mouth- like] (RBC’s Alterations)
Seen in patients with: Hereditary stomatocytosis (results in haemolytic anaemia)

Haematopoiesis Diagram
Haematopoiesis is the formation of blood cellular components. All cellular blood components are derived from haematopoietic stem cells.
Haematopoiesis

Alkaline Urine – Triple Phosphate Crystals
This is Alkaline Urine: notice triple phosphate crystals
These “triple phosphate” crystals look like rectangles, or coffin lids
Source & References: ...

Jaundice Symptoms and causes
Jaundice: is the yellowing of the skin and the eyes
1) Pre-hepatic (hemolytic): The pathology is occurring prior to the liver.
Sickle cell anemia
Spherocytosis
Thalassemia
G6PD deficiency
Hemolytic ...

Hypochromic microcytic anemia on peripheral smear
This is hypochormic microcytic anemia condition
Hypochormic as central pallor zone increased in most red cells
Microcytic as cells are smaller than normal
Anisocytosis (variation in ...
Neutrophilia – Leukomoid Reaction
An elevated WBC count with mainly neutrophils suggests inflammation or infection.
A very high WBC count (>50,000) that is not a leukemia is known as a “leukemoid reaction”.
This ...

Normal White Blood Cells on a Smear
Normal Lymphocyte on the left and Segmented Neutrophil on the right
Normal Monocyte, notice the folded nucleus and it’s big size comparing to other blood cells
Eosinophil ...

Normal Red Blood Cells on peripheral blood smear
This is a normal peripheral blood smear, you might notice very slightly anisocytosis and poikilocytosis
Red cells here are normochormic and central pallor is around 1/3 of cell diameter ...

Normal Bone Barrow
This is normal bone marrow smear at low power field magnification, you can see the erythroid island, granulocytes series and megakaryocytes.
This marrow is 50% cellular with steatocytes(1) ...

fragmented red blood cell or schistocyte
The image was captured from a case of β- thalassemia intermedia; findings include anisocytosis, poikilocytosis, hypochromia, target cells and many fragmented red blood cells
The arrow ...
